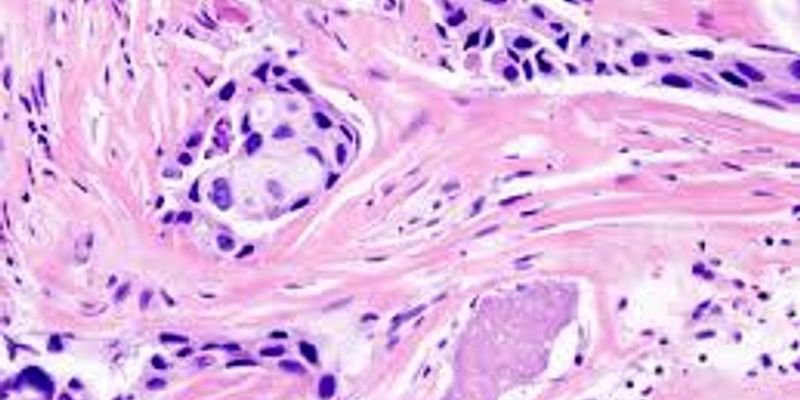

Anatomical Pathology
Anatomical Pathology: is a medical specialty that is concerned with the diagnosis of disease based on the macroscopic, microscopic, biochemical, immunologic and molecular examination of organs and tissues.
What's Popular in Anatomical Pathology
-
DEC 03, 2024ImmunologyJoin us to explore the latest insights into the future of precision oncology! This year, the Agilent Precision Oncology ...SEP 15, 2024Clinical & Molecular DXScientists have used computational tools, including machine learning, to differentiate between subtypes of rheumatoid ar ...Written By: Carmen LeitchMAR 27, 2023CancerInnate Immunity is a nonspecific host defense mechanism against foreign antigens. It is the first line of defense in a h ...Sponsored By: MBL InternationalNOV 01, 2021Cell & Molecular BiologyInflammatory bowel disease (IBD) is a term that describes chronic gut inflammation and includes ulcerative colitis and C ...Written By: Carmen LeitchSEP 23, 2021Cannabis SciencesInflammatory Bowel Disease (IBD) is a term used to describe chronic inflammation of the gastrointestinal tract. In gener ...Written By: Christopher DiMaio
DEC 03, 2024
Immunology
Join us to explore the latest insights into the future of precision oncology! This year, the Agilent Precision Oncology
...
SEP 15, 2024
Clinical & Molecular DX
Scientists have used computational tools, including machine learning, to differentiate between subtypes of rheumatoid ar
...
Written By:
Carmen Leitch
MAR 27, 2023
Cancer
Innate Immunity is a nonspecific host defense mechanism against foreign antigens. It is the first line of defense in a h
...
Sponsored By:
MBL International
NOV 01, 2021
Cell & Molecular Biology
Inflammatory bowel disease (IBD) is a term that describes chronic gut inflammation and includes ulcerative colitis and C
...
Written By:
Carmen Leitch
SEP 23, 2021
Cannabis Sciences
Inflammatory Bowel Disease (IBD) is a term used to describe chronic inflammation of the gastrointestinal tract. In gener
...
Written By:
Christopher DiMaio
SEP 10, 2021
Health & Medicine
Infective endocarditis is caused when a bacterium such as staphylococcus enters the bloodstream and infects heart
...
Written By:
Christopher DiMaio
OCT 30, 2020
Cancer
Research led by investigators at Flinders University in Australia is spearheading new developments in cancer prevention
...
Written By:
Kathryn DeMuth Sullivan
OCT 09, 2020
Cancer
In a new study reported in Clinical Cancer Informatics, an American Society of Clinical Oncology journal, medical provid
...
Written By:
Kathryn DeMuth Sullivan
OCT 01, 2020
Clinical & Molecular DX
It’s smaller than a human cell, but the diminutive size of the newly-developed ultrasound detector is by no means
...
Written By:
Tara Fernandes
-
MAR 26, 2024 | 7:00 PMC.E. CREDITSThe implementation of a preemptive pharmacogenomics (PGx) program in a hospital setting requires a multidisciplinary approach to ensure seamless integration of each stage of the process for...Speaker: Steven Melnick. Ph.D., M.D. , Dr. David Mancuso, Pharm.D. CPh , MSPMSponsored By: Thermo Fisher ScientificMAR 26, 2024 | 8:00 AMC.E. CREDITSThe implementation of a preemptive pharmacogenomics (PGx) program in a hospital setting requires a multidisciplinary approach to ensure seamless integration of each stage of the process for...Speaker: Steven Melnick. Ph.D., M.D. , Dr. David Mancuso, Pharm.D. CPh , MSPMSponsored By: Thermo Fisher ScientificMAR 12, 2024 | 10:00 AMIn this webinar, we will briefly introduce Vizgen’s Vizgen® MERSCOPE® Platform for spatial transcriptomics. Following this introduction, we will showcase the capabilities of ME...Gynecologic cancers account for nearly 40% of all cancer incidence and >30% of all cancer mortality in women worldwide. In recent years, there have been significant advancements in the cl...
OCT 30, 2023 | 8:00 PM
Description: Join this two-part webinar to learn how capillary electrophoresis (CE) complements sequencing technologies, such as next generation sequencing, that are being used by cancer res...
MAR 26, 2024 | 7:00 PM
C.E. CREDITS
The implementation of a preemptive pharmacogenomics (PGx) program in a hospital setting requires a multidisciplinary approach to ensure seamless integration of each stage of the process for...
Speaker:
Steven Melnick. Ph.D., M.D.
, Dr. David Mancuso, Pharm.D. CPh , MSPM
Sponsored By: Thermo Fisher Scientific
MAR 26, 2024 | 8:00 AM
C.E. CREDITS
The implementation of a preemptive pharmacogenomics (PGx) program in a hospital setting requires a multidisciplinary approach to ensure seamless integration of each stage of the process for...
Speaker:
Steven Melnick. Ph.D., M.D.
, Dr. David Mancuso, Pharm.D. CPh , MSPM
Sponsored By: Thermo Fisher Scientific
MAR 12, 2024 | 10:00 AM
In this webinar, we will briefly introduce Vizgen’s Vizgen® MERSCOPE® Platform for spatial transcriptomics. Following this introduction, we will showcase the capabilities of ME...
Gynecologic cancers account for nearly 40% of all cancer incidence and >30% of all cancer mortality in women worldwide. In recent years, there have been significant advancements in the cl...
OCT 30, 2023 | 8:00 PM
Description: Join this two-part webinar to learn how capillary electrophoresis (CE) complements sequencing technologies, such as next generation sequencing, that are being used by cancer res...
OCT 26, 2023 | 8:00 AM
Description: Join this two-part webinar to learn when capillary electrophoresis is an ideal choice relative to other various sequencing technologies – such as next generation sequencin...
OCT 10, 2023 | 10:00 AM
For patients with advanced non-small cell lung cancer (NSCLC), tissue samples are typically small biopsies. These samples undergo standard of care evaluation for >10 biomarkers to identif...
AUG 24, 2023 | 8:30 PM
When building your own infectious disease molecular panels there are many paths to consider. In this interview, we ask Marcus Cognetti and Dr. Ari Frenkel what approach is required to create...
The practice of pathology is rapidly undergoing a transformation in which multiple tools such as digital imaging, advanced artificial intelligence algorithms, and computer-aided diagnostic t...
-
DEC 05, 2025C.E. CREDITSStago EdVantage Virtual University is an educational platform that demystifies hemostasis testing with on-demand webinars and a virtual exhibit hall that ......FEB 29, 2024 | 12:00 PM PSTC.E. CREDITSPrecision medicine in solid tumors is transforming the testing and treatment of cancer. You can be part of this exciting field by joining our one-day virtual event. Some of the highlights of...APR 26, 2023 | 9:00 AM PDTIn this Lab Week virtual symposium, bioMérieux celebrates Medical Laboratory Professionals by providing education and learning opportunities to support the life-changing work you and your lab...It’s an Open House! Come join us virtually where you will have the opportunity to network with colleagues and learn about the latest developments in life science research. The Leica Bi...10/14-15 9am-1pm CDTComing to you from a safe, physical distance, 2020 Abbott World Summit. This event will feature over 15 global experts sharing their latest discoveries and experiences in cancer screening, r...
DEC 05, 2025
C.E. CREDITS
Stago EdVantage Virtual University is an educational platform that demystifies hemostasis testing with on-demand webinars and a virtual exhibit hall that ......
FEB 29, 2024
| 12:00 PM PST
C.E. CREDITS
Precision medicine in solid tumors is transforming the testing and treatment of cancer. You can be part of this exciting field by joining our one-day virtual event. Some of the highlights of...
APR 26, 2023
| 9:00 AM PDT
In this Lab Week virtual symposium, bioMérieux celebrates Medical Laboratory Professionals by providing education and learning opportunities to support the life-changing work you and your lab...
It’s an Open House! Come join us virtually where you will have the opportunity to network with colleagues and learn about the latest developments in life science research. The Leica Bi...
10/14-15 9am-1pm CDT
Coming to you from a safe, physical distance, 2020 Abbott World Summit. This event will feature over 15 global experts sharing their latest discoveries and experiences in cancer screening, r...
10/13-14 from 1-5pm SGT
Coming to you from a safe, physical distance, Abbott 2020 world oncology summit. Covering diverse and timely topics in cancer education, from updates in cancer emerging new diagnostics resea...
SEP 29, 2020
| 6:00 AM PDT
Due to the fact that many large events and scientific conferences have been cancelled, we want to provide you with an outlet to present your research and learn from others in our community....
APR 10, 2019
| 6:00 AM PDT
The 4th Annual Event in the Molecular Diagnostics Virtual Event Series is now available On Demand!...
OCT 10, 2018
| 6:00 AM PDT
The 6th Annual Event in the Cancer Research & Oncology Week Virtual Event Series will take place October 2018....